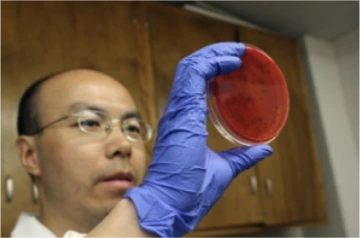

Sadhana Ravishankar, Ph.D.
Professor - Food Safety
sadhravi@arizona.edu
520-626-1499
The courses I teach and a few of my research projects include: MIC 430/530- Food Microbiology & Biotechnology; MIC 205A- General Microbiology; MIC 205L- Biology of Microorganisms Laboratory; Improving the Safety & Quality of Organic Leafy Greens: assessment of good agricultural/production practices along the farm-to-fork continuum, Assessing contamination risk associated with dust, soil, compost and contaminated irrigation water as pathogen transfer vehicles to iceberg lettuce, Ozonated water and plant antimicrobials: A quick and effective method to inactivate Salmonella enterica on iceberg lettuce, On farm evaluation of the prevalence of human enteric bacterial pathogens during the production of melons in California and Arizona, Culturability of pathogens from produce wash water and irrigation water, Evaluation of attachment strength of Salmonella enterica to conventional and organic soils, Use of CHICO wash to control foodborne pathogens in vitro and on foods. Aside from microbiology and food safety, I enjoy gardening and music.
Libin Zhu, M.S.
Lab Manager and Research Specialist
zhulibin@arizona.edu
My research projects include: using plant compounds, organic sanitizers and edible films to control foodborne pathogenic bacteria on organic leafy greens, cantaloupes and other foods; the survival of foodborne pathogens on leafy greens grown under different conditions and in irrigation waters from the growing region; the antimicrobial effects of natural plant compounds in grilled meats the potential use of copper alloys as antimicrobial food contact surfaces as an alternative to stainless steel

Bibiana Law, Ph.D., M.B.A.
Researcher/Scientist III
bibiana@arizona.edu
I assist on the business aspects of the projects including on the management of intellectual property, experimental design, funding and execution of projects, and cost analyses to develop products for commercial purposes, as well as with collaboration and providing microbiological research and testing services for industry.

Richard Park, B.Sc.
Research Laboratory Assistant
rjpark@arizona.edu
I received my bachelor's degree from the University of Arizona in 2018. My main focus is the transfer of foodborne pathogens from the soil and dust onto the melon rind surface. The specific foodborne pathogens of interest are Salmonella and Listeria.

Kirat Khushwinder Bains
kiratkbains@arizona.edu
Research Laboratory Assistant
I am a second year PhD student in Ravishankar lab. I work on a project aimed at prevention of
biofilms on food contact surfaces using plant-based antimicrobials. I have also worked on other
projects such as attachment strength of foodborne pathogens on melon rinds and testing
efficacy of plant-based antimicrobials on different food contact surfaces. When I am not
working in the lab, I like cooking, dancing, and going for a hike.

Luis Andres Rodriguez Medina,
Master's student,
rodriguezmedina@arizona.edu
I’m Luis A Rodriguez, a graduate student in the Applied Biosciences Professional Science
Master Program in the Medical Microbiology and Immunology track. I obtained my bachelor’s
degree in biology with an emphasis in biomedical sciences from the University of Puerto Rico-
Aguadilla Campus. My research focus in Dr. Ravishankar’s laboratory is to research the
efficiency of plant-based sanitizers against foodborne pathogens in different food products. Also,
the research is investigating a novel delivery technique for the sanitizers that can be applied in
the food industry.

Vanshika chauhan
Master's student
vanshikachauhan@arizona.edu
I am a graduate student in Professional Science master's Applied Biosciences - Industrial Microbial Biotechnology, University of Arizona. I joined Dr. Ravishankar's lab in Spring 2023 as a volunteer. I've been training, learning and assisting in ongoing projects related to plant-based antimicrobials, sampling different food products in order to study their shelf life and how to increase it. When I'm not in the lab I like to paint, cook and travel.

Likitha raj Mudigonda
Master's student
likitham@arizona.edu
I, Likitha Raj, am a graduate student in the Applied Biosciences- IMB track. I have obtained my Bachelor's degree in Biotechnology from SRM University, and am presently engaged in plant-based sanitizers in opposition to foodborne pathogens. Additionally, I am working on the website for laboratory.
Past members:

Astrid Cambuston
Undergraduate Student
acambuston@arizona.edu
I am currently a senior pursuing a major in Microbiology and joined Dr. Ravishankar’s lab in 2021. I am responsible for preparing the media, broths, peptone tube racks, and reagents. Additionally, I manage lab maintenance such as organizing and sterilizing supplies, glassware, equipment and removing waste materials. Furthermore, I got the opportunity to apply food safety techniques and learned alternative antimicrobials for treatment solutions. I also help my supervisor and Dr. Ravishankar by analyzing literature reviews, executing lab tours, and training individuals working in the laboratory.

Kristina Raygoza
Undergraduate student
kristinaraygoza@arizona.edu
My name is Kristina Raygoza and I worked in Dr. Ravishankar’s lab during the duration of my time at the University of Arizona. While working with Dr. Ravishankar I got to catch the tail end of the cantaloupe project and work on some posters and research papers for this research. I loved my time working in this lab and the experiences that I gained from them.

David Rowland, B.Sc.
Research Technician
davidrowlands@email.arizona.edu
I am a University of Arizona graduate working in Dr. Ravishankar’s lab as a Research Technician. I work on several projects including on the attachment strength of foodborne pathogens on melon rinds, determining the shelf life of melons, and on the prevention of biofilms. When I am not working in the lab, I enjoy reading, playing Dungeons & Dragons, board games, and listening to true crime podcasts.

Stephanie Arellano
Master's student
sarellano@email.arizona.edu
My name is Stephanie Arellano, I am a 2nd year graduate student in the Applied Biosciences-Professional Sciences Masters program. My major is in Medical Microbiology and Immunology, however I have shifted my focus towards Food Microbiology and Food Safety. I am in Dr. Ravishankar’s lab currently investigating the efficacy of plant derived antimicrobials against foodborne pathogens Salmonella Newport, and Escherichia coli O157:H7, as well as spoilage organism, Lactobacillus casei while also evaluating the shelf life of Iceberg lettuce that has been treated with the antimicrobial microemulsions. Whenever I am not in the lab, I enjoy working out, playing tennis, reading, or watching movies.

Vimarys Oliveras
Undergraduate Student
vimarysoliveras@email.arizona.edu
My name is Vimarys Oliveras. I am from Puerto Rico and I started as a volunteer in Dr. Ravishankar’s lab around 2018. Currently, I am an undergraduate senior working as a work-study student in Dr. Ravishankar’s lab. As I continue working in this lab, I learned to make various types of media for lab projects, helped with graduate projects, and also mentored and trained new volunteers in media preparation for Dr. Ravishankar’s lab. In addition, I was offered the opportunity to work on my first independent project as an undergraduate. During Summer 2019, I had the opportunity to start the CONSERVE Summer Internship Program at the University of Arizona. As of today, I have presented my project in front of staff members at the University of Arizona and agricultural professionals at the Southwest Ag Summit.

Jocelyn Rossete
Undergraduate Student
jorl123@email.arizona.edu
I am currently pursuing my Bachelor of Science in Microbiology with a minor in Military Science. I have a great interest in the development of food safety policies and the implementation of food safety practices. I currently hold the position of Undergraduate Student Researcher at Dr. Sadhana Ravishankar's research lab at The University of Arizona. I participate in outreach activities where we inform the public about the prevention of foodborne illnesses and the use of natural antimicrobials. I facilitated hands-on experiments for an average of 50-70 high school students participating in the U.S Department of Agriculture (USDA) summer program. I assisted in the preparation of samples for sensory tests in the application of natural antimicrobials in produce and meat products. I plan and prepare weekly media for outgoing experiments.

Noor Juboori
Undergraduate Student
noorjuboori@email.arizona.edu
I am a junior student studying Microbiology at the University of Arizona. I started volunteering in Dr. Ravishankar’s lab since Fall 2019 until now. I assist with experiments and making media as well as assisting everyone in the lab when I am free. Since I have worked in the lab, I learned a lot about the properties of bacteria and different behaviors of microbes that affects our food and a lot of information about pathogens that cause illnesses.

Samantha Mendieta
Undergraduate Student
smendieta@email.arizona.edu
I am from southern California and currently a senior studying Veterinary Sciences with a minor in Ecology Evolutionary Biology. I am currently volunteering in Dr. Ravishankar’s lab by making media, broths, peptone tube racks, and lab clean up. Whenever I’m not making media, I like to shadow and help with whomever has any current projects in the lab. Volunteering here has helped me gain more knowledge and lab experience in microbiology techniques

Aishwarya Rao, M.S.
Research Technician
aishwaryarao@email.arizona.edu
I came to the University of Arizona with a Bachelors in Chemistry, Botany and Microbiology and a Masters in Biotechnology. Under Dr. Ravishankar’s mentorship, I worked on leafy greens and a host of natural antimicrobials, looking at survival of foodborne pathogens as well as the sensory attributes of the compounds. I spent my time at the UA doing research, teaching MIC 205 and 421 and being the CALS representative at the Graduate and Professional Student Council (GPSC). After graduating with a Masters in Microbiology, I’m working as a Research Technician on the biofilms, CONSERVE and melons projects while mentoring the undergraduates in our lab. Apart from being enthusiastic about sports and science, I enjoy volunteering at the Humane Society and watching crime fighting TV shows. When I’m not at the lab, you can find me at Zumba or the gym.

Qi Wei, Ph.D.
Visiting Scholar
weiqi@email.arizona.edu
I am a Ph.D. student from Fujian Agriculture and Forestry University in China. My major is Food Science and Engineering. As a research scholar I worked in Dr. Ravishankar’ lab where the focus was on the attachment strength of melons; safety and quality of non-traditional sources of irrigation water; treatment technologies for non-traditional sources of irrigation water; and biofilm formation on various food contact surfaces and their prevention using natural sanitizers.

Monique Torres, B.Sc.
Research Assistant
matorres@email.arizona.edu
I was born and raised in Tucson, AZ. I graduated from The University of Arizona with a Bachelor’s of Science in Veterinary Science in 2013. I worked in Dr. John Marchello's lab at the UA Food Products and Safety Lab (FPSL) for several months in 2014. At the FPSL, I learned to test foods for moisture content, protein, lipids, and more and from this information, I was able to calculate and create nutrition labels for food products. I also gained experience of processing meat animals for human consumption and learned all about meat quality and meat safety. I was then transferred to Dr. Sadhana Ravishankar’s Lab in February of 2015. Under Dr. Ravishankar, I was able to do research on foodborne pathogens isolated from livestock and determined their antibiotic susceptibility profiles. Dr. Ravishankar’s lab is where I learned my fundamental microbiology lab work. I learned basic microbiology such as making media, streaking for isolation, spread plating, serial dilutions, and much more. I also learned some molecular microbiology such as DNA extractions, conventional PCR, and gel electrophoresis. I learned proper sampling techniques, food/produce safety, foodborne pathogens, and natural and chemical antimicrobials. I graduated and received my Master of Science in Animal Science in Fall of 2016. Working under Dr. Ravishankar made this the best possible experience I could have had in graduate school. She was and still is a wonderful advisor, kind, caring, patient, understanding, and so much more. I really enjoyed my graduate career because I was in a positive, encouraging, and challenging learning environment. In February of 2017, I started working as a research technician full time in Dr. Charles P. Gerba lab under Dr. Kelly Bright. In this lab, I collected irrigation water samples from various areas of Southern Arizona and looked for the prevalence of Salmonella and fecal indicator organisms. In Fall 2017, I enrolled as a PhD applicant in the SWES department for Environmental Science. I then switched to a MS in Environmental Science in February of 2018 because I did not have a strong interest in the subject. I did some lab work for Dr. Ravishankar from March 2018 to August 2018 and worked on determining the attachment strength of Listeria monocytogenes and Salmonella enterica on various melon rinds. Currently, I am working on completing the writing for my thesis and plan to graduate fall 2018.

Hunter Cole
Undergraduate Student
ghcole@email.arizona.edu
I am from the rural community of Oracle, AZ and a senior microbiology major. I make media for the lab as well as assist in various projects. After I graduate, I hope to further my education and become a Research Scientist.

Emily Napoles
Undergraduate Student
enapoles@email.arizona.edu
I am a senior studying veterinary science and getting a minor in microbiology. I worked in Dr. Ravishankar’s lab in the summer of 2018, assisting with making media and the on-going projects. I’m learning a lot about the properties of bacteria binding to the rind of cantaloupes. I’m enthusiastic about learning the behaviors of different microbes and the prevalence of potential pathogens in our foods and all around us. I believe it’s important to develop more information about the pathogens and how to prevent them from causing illnesses in populations.

Mai Nguyen
Undergraduate Student
pnguyen61@email.arizona.edu
I am a junior studying microbiology and food safety at the University of Arizona. As an intern, I assist in making media and assist in experiments. I started interning at the lab in the fall of 2017. This summer, I was able to intern with Dr. Ravishankar under the CONSERVE Water Internship. During this internship, I worked on antibiotic susceptibility of water isolate samples. I am planning to continue this project and working in the lab.

Angelica Padilla
Undergraduate Student
angelicapadilla@arizona.edu
I am a senior studying microbiology and currently am volunteering in Dr. Ravishankar's lab in order to develop stronger laboratory techniques. The microbial world has always interested me, and being a part of this lab allows me to work with something I enjoy.

Valeria Padilla
Undergraduate Student
valeriapadilla@arizona.edu
Volunteering in Dr. Ravishankar's research lab as a senior studying Microbiology has prepped me in new ways as I am gaining an understanding of diverse work strategies in the lab while enjoying the pleasure of collaborating in a team. A few projects that I assist with include counting colonies of Salmonella or Listeria, spread-plating, and making agar plates. I chose to be a part of this lab in particular because I found great interest in the efforts to research the association of bacteria and a common food item in attempting to have a product that is safer for human consumption. This opportunity to help me grow in this field is one I am grateful for. It's helping me go forward in perfecting and acquiring the laboratory performances that, as a microbiologist, are essential.